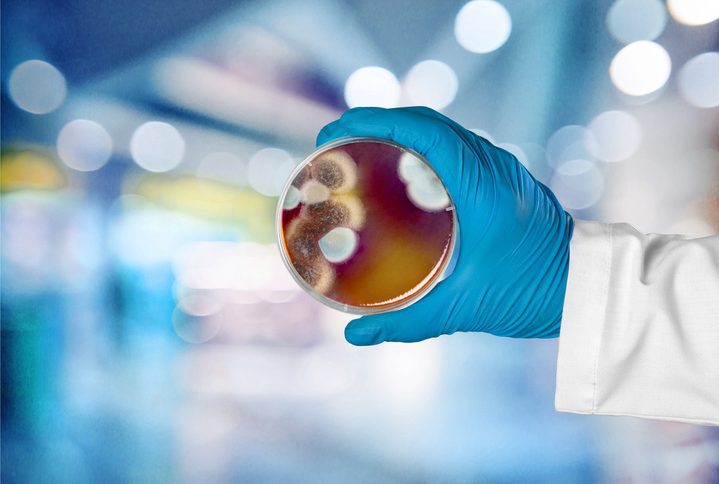
Microbiology laboratory test in scientist hand on background

- Find our latest Case Studies
- Our Platforms
Our Platforms
- Platform 1: Bioactives Library – Shaping novel antimicrobial products
- Platform 2: Hits to Leads – Developing new innovative antibiotics
- Platform 3: Organoid modelling – Enhancing drug discovery
- Platform 4: Advanced AMR Modelling
- Platform 5: Human Challenge – Small scale clinical trials
- Platform 6: Diagnostics
- Platform 7: Randomised Control Trials
- Platform 8: Mapping and Modelling
- Platform 9: Nanotherapeutics
- Platform 10: Antibody Humanisation
- Platform 11: Long-Acting Therapeutics